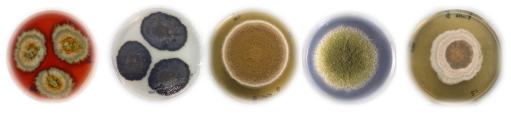

Mae Dr Claudio Greco wedi gweithio ym Mhrifysgol Abertawe ers 2022. Mae gwaith ymchwil Claudio'n canolbwyntio ar ddarganfod a datblygu cynhyrchion naturiol, gyda ffocws penodol ar ffyngau. Ynghyd â'i waith ymchwil, mae Claudio'n goruchwylio myfyrwyr PhD ac yn addysgu myfyrwyr y Biowyddorau yn y flwyddyn gyntaf a'r drydedd flwyddyn.
Dywedwch wrthyf am eich rôl...
Rwyf wedi bod yn ddarlithydd yn adran y Biowyddorau ym Mhrifysgol Abertawe ers tair blynedd, ac rwy'n addysgu'r modiwl biotechnoleg cynhyrchion naturiol i fyfyrwyr y drydedd flwyddyn ar hyn o bryd. Y tu allan i ddarlithio, fy rôl yw arwain fy ngrŵp ymchwil o'r enw Microbioleg Synthetig a Chynnyrch Naturiol. Mae diddordeb gennym mewn darganfod cynhyrchion naturiol o ficrobau, yn enwedig ffyngau.
Meysydd arbenigedd?
Mae fy hyfforddiant rhwng cemeg, a astudiais fel myfyrwyr israddedig, a chemeg fiolegol/microbioleg, sef ffocws fy PhD. Mae fy arbenigedd yn bennaf yn ymwneud â chynhyrchion naturiol ffyngaidd, biosynthesis, egluro strwythur gan ddefnyddio offer cemegol a geneteg ffyngaidd. Mae gan fy labordy arbenigedd cryf wrth ddatblygu offer genetig i addasu'r genom ffyngaidd i archwilio a darganfod cynhyrchion naturiol.
Penderfynais ddilyn fy niddordeb mewn ffyngau ar ôl hyfforddi mewn synthesis organig. Dywedodd un o'm goruchwylwyr wrthyf fod prosiect a oedd wrth y croestoriad rhwng microbioleg a chemeg ac roeddent yn ceisio darganfod cynhyrchion naturiol o rywogaethau ffyngaidd ar gyfer cymwysiadau agrocemegol. Arweiniodd y cyfle hwn ataf yn gweithio gyda Syngenta a chael mwy o brofiad ymarferol.
Roedd diddordeb gennyf erioed mewn synthesis a biosynthesis cynhyrchion naturiol a daeth fy niddordeb mewn ffyngau'n ddiweddarach. Bûm yn gweithio ar synthesis cyfan, a chyda bacteria, ond erbyn hyn rwy'n canolbwyntio'n bennaf ar fetabolynnau eilaidd ffyngaidd.

Sut defnyddir ffyngau?
Mae ffyngau'n organebau anhygoel sydd i'w cael ym mhob agwedd ar fywyd, gan gynnwys yn ein cyrff. Mae ganddynt rôl hollbwysig wrth gydbwyso amgylcheddau, ac maen nhw'n cynhyrchu amrywiaeth o fetabolynnau sy’n gwneud gwaith pwysig ar gyfer darganfod cyffuriau. Gellir defnyddio ffyngau hefyd fel biomas i greu bioddeunyddiau cynaliadwy. O'm safbwynt i, mae ffyngau'n wych am gynhyrchu moleciwlau bioactif sydd â rolau ecolegol pwysig a'r potensial i gael eu cynnwys mewn meddygaeth ac amaethyddiaeth.
Gallwch ddod o hyd i ffyngau mewn cynhyrchion bwyd, yn enwedig fel ffynhonnell o brotein mewn bwydydd llysieuol a fegan amgen. Mae ffyngau'n gyfoethog mewn protein yn ogystal â bod yn ffynhonnell gynaliadwy o fwyd. Gallwch eu tyfu nhw mewn bioadweithydd, sy'n golygu nad yw amodau amgylcheddol yn effeithio arnynt, gan gynnwys y tywydd neu wrth ddefnyddio blaladdwyr. Maen nhw'n cael eu defnyddio i gynhyrchu meddyginiaethau megis penisilin, ac mae eu priodweddau manteisiol wedi cael eu defnyddio drwy gydol hanes.
Beth yw cynnyrch naturiol i chi?
Unrhyw beth sydd wedi'i gysylltu â ffynhonnell naturiol. I rai, gallai hyn olygu defnyddio micro-organeb gyfan, ond o'm safbwynt i mae'n golygu canolbwyntio ar foleciwlau bach a elwir yn fetabolynnau eilaidd.
Sut rydych chi'n gweithio gyda'r BioHYB Cynhyrchion Naturiol ar hyn o bryd?
Rwyf wedi bod yn rhan o sawl prosiect, ac rydym wedi cyflwyno ceisiadau am grantiau gyda'n gilydd. Rwyf hefyd yn gyd-oruchwyliwr rhai myfyrwyr a myfyrwyr ôl-ddoethurol gydag aelodau eraill o dîm y BioHYB Cynhyrchion Naturiol. Fy meysydd arbenigedd yw cemeg ddadansoddol, megis sbectrometreg màs, puro cemegol yn ogystal â microbioleg, geneteg ffyngaidd a biowybodeg. Mae'r ystod hon o arbenigedd rhwng cemeg a microbioleg yn fy ngalluogi i gefnogi llawer o brosiectau'r BioHYB.
Sut gallwch chi helpu cwmnïau sy'n gweithio gyda GEC?
Nid yw'n benodol i sector, ond gall fy ngwybodaeth fod yn ddefnyddiol i'r diwydiannau cemegion amaethyddol, meddygol a bwyd. Rwy'n hapus i gefnogi gwaith i ddarganfod cynhyrchion naturiol ffyngaidd, peirianneg straen, dadansoddiad cemegol a biosynthesis. Yn ogystal, mae gan fy ngrŵp fynediad at ystod o gyfarpar arbenigol megis UHPLC-HRMS, HPLC paratoadol, cyfleuster echdynnu cemegol a chyfarpar microbiolegol i weithio gydag organebau CAT-I a CAT-II. Mae gennyf ddiddordeb mewn gweithio gyda chwmnïau a datblygu prosiectau gyda'n gilydd.
Prosiectau presennol...
Ar hyn o bryd, dwi'n gweithio ar ddau brif brosiect. Mae'r cyntaf yn gydweithrediad â Gwlad Thai, lle rydym yn sgrinio casgliad ffyngaidd Thai enfawr er mwyn darganfod straeniau newydd y gellir eu defnyddio fel bioreolwyr ac sy’n gallu cynhyrchu cynhyrchion naturiol bioactif i ymladd yn erbyn amrywiaeth o glefydau planhigion. Mae'r prosiect yn parhau, ond rydym eisoes wedi darganfod straeniau ffyngaidd cyffrous sydd â photensial gwych i amddiffyn cnydau gwahanol. Mae'r ail brosiect yn edrych ar rôl cynhyrchion naturiol ym microbïom morgrug deildorrol. Mae gennyf ddiddordeb mawr mewn deall potensial biosynthetig pathogen ffyngaidd a sut mae ei foleciwlau bach yn cael eu defnyddio yn erbyn organebau eraill.
Prosiectau ar gyfer y dyfodol
Gallai fy mhrosiect presennol gyda Gwlad Thai elwa o gael rhywun penodol i ddatblygu offer genetig i ddatblygu'r prosiect ac efallai ysgogi cydweithrediadau diwydiannol hefyd. Mae gennyf ddiddordeb hefyd mewn datblygu casgliad o ffyngau o Gymru a darganfod cynhyrchion naturiol ffyngaidd newydd.
Os oes diddordeb gennych mewn gweithio gyda mi, e-bostiwch claudio.greco@abertawe.ac.uk ac edrychwch ar fy ngwefan >> www.grecolab.com